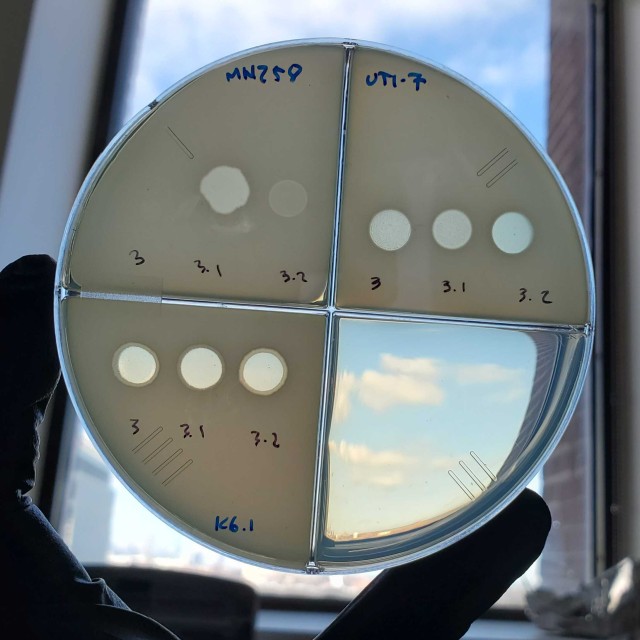

Welcome to the Department of Microbiology
Research
Basic research in Microbiology seeks to address how microbes shape our world and to develop insight to advance the prevention and treatment of human diseases.
The discoveries of microbes and the realization that they represent causative agents of human, animal, and plant diseases have transformed biological sciences and established the very broad foundations of molecular medicine. Faculty in the Department of Microbiology research different microbes including bacteria (pathogenic Bacillus, Clostridium, Enterococcus, Klebsiella, Listeria, Mycobacterium, Staphylococcus, Yersinia, and commensal species, including the Bacteroidales) and viruses (Hepatitis C, Dengue, SARS-CoV-2, Zika, and several retroviruses and arenaviruses). In collaboration with the Duchossois Family Institute (Harnessing the Microbiome and Immunity for Human Health), the Pritzker School of Molecular Engineering, and U. Chicago Medicine, our faculty investigate the organizing principles of the microbiome, its role in maintaining health and preventing disease, and the development of novel therapies.

Education
Our curriculum provides broad exposure to multiple disciplines in microbial science, and supports specialized training in several areas of interest.
Undergraduates majoring in Biological Sciences with a Specialization in Microbiology take at least five courses. Graduate students pursuing a PhD in Microbiology take a minimum of nine courses. Students consult the Graduate Advisor of the Committee on Microbiology to develop a plan of study that fulfills the program course requirements and meets the student’s particular interests in microbiology. The philosophy of graduate coursework is to develop a foundation of knowledge for the first-year graduate student. Of course, the basis of graduate training in microbiology is the performance of original laboratory research, which begins in winter or spring of the first year.


